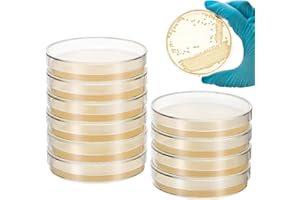
SHINEOFI 10pcs Nutrient Agar Petri Dishes, 7cm Pre-poured Agar Plates for Laboratory Use School Projects And Research Science Experiment Prepoured Supplies

SHINEOFI best sellers
Get a list of 44 SHINEOFI best sellers on Amazon . Period is past 7 days, last updated 2025-01-13.

|
#1 Acrylic Desk Organizer £11.74 on Amazon |
|

|
#2 16Pcs White Masquerade £14.89 on Amazon |
|

|
#3 2pcs Cute Mini Knitted £9.29 on Amazon |
|
|
#4 🔥 🆕 10pcs Nutrient Agar Petri £19.19 on Amazon |
|

|
#5 2pcs Mini Knitted Hats £8.79 on Amazon |
|

|
#6 🔥 Desk Calendar 2025 2026 £7.99 on Amazon |
|

|
#7 Aerosol can Valve Extension £12.99 on Amazon |
|

|
#8 🆕 620G Portable Car Fire £28.49 on Amazon |
|

|
#9 60Pcs Wooden Rounds for £13.19 on Amazon |
|

|
#10 🔥 🆕 Flat Bamboo Strip Webbing £5.92 on Amazon |
|

|
#11 🔥 SHINEOFI Traffic Light £9.39 on Amazon |
|

|
#12 🔥 🆕 Desk Calendar 2025 2026 £10.59 on Amazon |
|

|
#13 20pcs Crochet Flower £8.19 on Amazon |
|

|
#14 6 Sheets Adhesive Felt £10.99 on Amazon |
|

|
#15 1PCS First Day of School £11.39 on Amazon |
|

|
#16 DC Power Supply Adapter £8.99 on Amazon |
|

|
#17 Reusable Tube Holders £11.78 on Amazon |
|

|
#18 First and of School Board £7.99 on Amazon |
|

|
#19 Mini Desk Calendar 2024 2025 £2.15 on Amazon |
|

|
#20 Buddhist Pouch Storage £7.99 on Amazon |
Suggested best sellers
What's in Bestsellers.ai PRO ?
- 📊 Product Sales Estimates
- 💰 Total Sales Estimates
- 📜 Product Sales history
- 📅 52-Week Sales estimates
- 🔍 Advanced filtering
- ♻️ Second Hand and Refurbished market Data
Who uses Bestsellers.ai PRO ?
Trusted by e-merchants everywhere, Bestsellers.ai is their go-to for deciding what to sell next. Leading brands and retailers rely on us for crucial competitor insights and data-driven choices. 🚀
